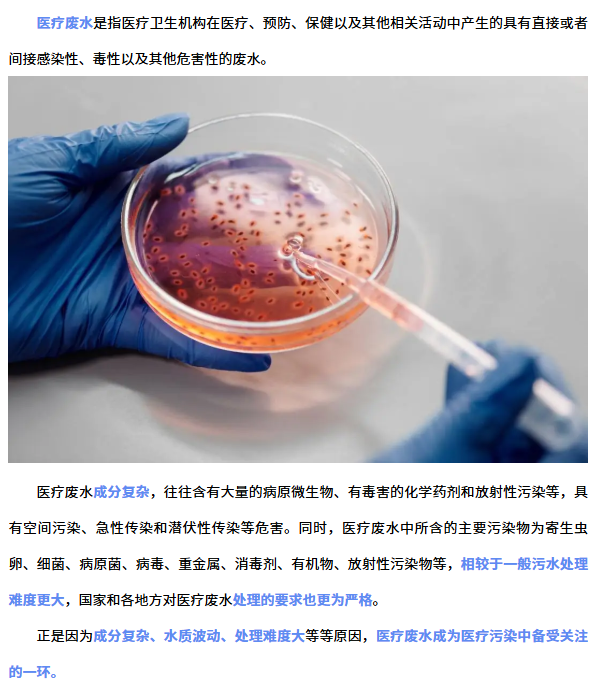

近日咸阳市生态环境局高新分局对全区医疗机构开展环境监测数据弄虚作假专项整治活动。而不久前,汉中市发布的2023年重点建设项目计划表中也有多个医疗废物处置中心建设项目,可见陕西省近来对医疗污染问题重点聚焦。

其实不止陕西,全国多地近期都在围绕医疗机构排污问题展开措施。
湖南省在省生态文明建设专场会议上也强调全省加强医疗废物、医疗废水监管,确保医疗机构及设施环境监管和服务100%全覆盖。
重庆建成固体废物大数据平台,2.3万家危险废物产生单位和2.23万家医疗机构纳入平台管理,渝中区、江北区发布医疗废物规范化管理指南。

云南省昆明市生态环境局起草了《昆明市医疗废物管理规定(修订)》文本,并公布修订征求意见稿。
海南省三亚市人民政府发布《三亚市危险废物管理办法(试行)》,要求医疗卫生机构和医疗废物集中处置单位,应当采取有效措施,防止医疗废物流失、泄漏、渗漏、扩散。

医疗废水的处理往往要根据医院的规模、性质以及污水排放去向,选择不同的工艺来处理。一般采用的工艺有一级处理、二级处理和简易生化处理三种方式。

达泽环保深耕医疗废水处理领域多年,对于医疗废水处理有着成熟的工艺技术和丰富的项目经验,为各大医疗机构提供50-3000吨不等的水量处理服务。
通过工艺段的设计组合,可以有效去除废水中的有害物质,保障出水达标。达泽对医疗废水处理工艺流程设计完善,做到“水、泥、气、消毒”流程全覆盖,充分落实无害化处理,搭载智能运维系统,实现系统智能化管理和运维,提高整体运行效率和稳定性。

针对部分医疗机构疾控防治等特殊排放要求,达泽可以通过采取运行参数调整,加强污水检测频率、提高消毒剂使用量等措施,保障废水处理系统稳定运行、长效达标。
案例名称:南医大四附院污水处理运维服务采购项目
运行规模:2000m³/d

案例名称:南京医科大学附属逸夫医院污水处理站建设工程
项目规模:1200m³/d

案例名称:江宁区中医院污水处理工程
项目规模:1000m³/d

案例名称:江苏省人民医院浦口分院医疗污 水处理设备 采购、安装项目
项目规模:1000m³/d

案例名称:界首市人民医院(某区新院)污水处理工程项目
项目规模:850m³/d

达泽环保18年专注于水污染治理
集研发、设计、生产、安装、调试、运维于一体
具备设计、施工、运维等 9 项行业资质
选择达泽环保,共创绿色家园!
